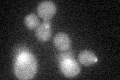
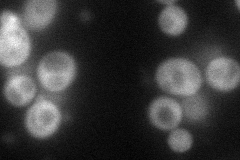
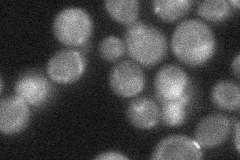
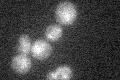

View description
Serine/threonine protein kinase involved in regulation of exocytosis; localizes to the cytoplasmic face of the plasma membrane; closely related to Kin1p
Localization:
Intensity:
Fold change:
Significance:
-
C’ GFP library in SD
cytosol24.26 -
N' NOP1pr-GFP in SD
cytosol67.5869 -
N' TEF2pr-mCherry in SD

cytosol59.4721 -
N' NATIVEpr-GFP in SD
cytosol31.423 -
N' TEF2pr-VC and Cyto-VN in SD

cytosol47.0191 -
C’ GFP library in SD+DTT

cytosol21.470.88No -
C’ GFP library in SD+H2O2

cytosol22.50.92No -
C’ GFP library in Starvation Media
cytosol20.370.83No -
C’ GFP library on the background of Pup2-DaMP

cytosol -
C’ GFP library on the background of CCT mutant

cytosol21.6690.892896No
